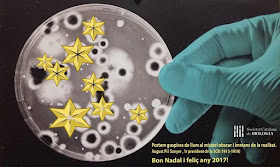

Bones festes a tots els lectors del blog adn-dna, usuaris dels recursos de ciències de la naturalesa adn-dna.net i seguidors a Twitter: adn-dnanet
Es pot utilitzar utilitzar l'espai de comentaris d'aquest post per escriure la felicitació de les festes i penjar els seus desitjos pel 2017.
Nota: En fer els comentaris cal seguir les recomanacions indicades en el post 341 d'aquest blog adn-dna.